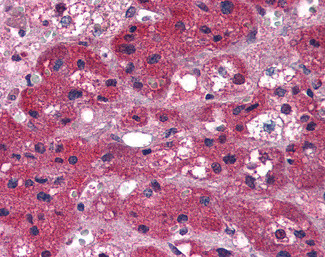
ARIH1 Antibody in Immunohistochemistry (Paraffin) (IHC (P))

Search
Invitrogen
ARIH1 Polyclonal Antibody
{{$productOrderCtrl.translations['antibody.pdp.commerceCard.promotion.promotions']}}
{{$productOrderCtrl.translations['antibody.pdp.commerceCard.promotion.viewpromo']}}
{{$productOrderCtrl.translations['antibody.pdp.commerceCard.promotion.promocode']}}: {{promo.promoCode}} {{promo.promoTitle}} {{promo.promoDescription}}. {{$productOrderCtrl.translations['antibody.pdp.commerceCard.promotion.learnmore']}}


Please note: We are reviewing Western blot images included in the antibody testing data in our catalog, including those provided by third parties. Unless expressly labeled or annotated as “raw-unedited”, Western blot images included in the antibody testing data in our catalog may have been edited, optimized or otherwise adjusted for presentation.
产品信息
PA5-18125
种属反应
宿主/亚型
分类
类型
抗原
偶联物
形式
浓度
规格
纯化类型
保存液
内含物
保存条件
运输条件
RRID
产品详细信息
This antibody is predicted to react with bovine and mouse based on sequence homology.
This antibody is tested in Peptide ELISA: antibody detection limit dilution 32,000.
靶标信息
E3 ubiquitin-protein ligase, which catalyzes ubiquitination of target proteins together with ubiquitin-conjugating enzyme E2 UBE2L3 (PubMed:15236971, PubMed:21532592, PubMed:24076655, PubMed:27565346, PubMed:23707686). Acts as an atypical E3 ubiquitin-protein ligase by working together with cullin-RING ubiquitin ligase (CRL) complexes and initiating ubiquitination of CRL substrates: associates with CRL complexes and specifically mediates addition of the first ubiquitin on CRLs targets (PubMed:27565346). The initial ubiquitin is then elongated by CDC34/UBE2R1 and UBE2R2 (PubMed:27565346). E3 ubiquitin-protein ligase activity is activated upon binding to neddylated cullin-RING ubiquitin ligase complexes (PubMed:24076655, PubMed:27565346). Plays a role in protein translation in response to DNA damage by mediating ubiquitination of EIF4E2, the consequences of EIF4E2 ubiquitination are however unclear (PubMed:25624349). According to a report, EIF4E2 ubiquitination leads to promote EIF4E2 cap-binding and protein translation arrest (PubMed:25624349). According to another report EIF4E2 ubiquitination leads to its subsequent degradation (PubMed:14623119). Acts as the ligase involved in ISGylation of EIF4E2 (PubMed:17289916). In vitro, controls the degradation of the LINC (LInker of Nucleoskeleton and Cytoskeleton) complex member SUN2 and may therefore have a role in the formation and localization of the LINC complex, and as a consequence, nuclear subcellular localization and nuclear morphology (PubMed:29689197). [UniProt]
仅用于科研。不用于诊断过程。未经明确授权不得转售。
篇参考文献 (0)
生物信息学
蛋白别名: ARI-1; DKFZp686O13120; E3 ubiquitin-protein ligase ARIH1; FLJ20329; FLJ93118; H7-AP2; HHARI; Monocyte protein 6; MOP-6; Protein ariadne-1 homolog; UbcH7-binding protein; UbcM4-interacting protein; Ubiquitin-conjugating enzyme E2-binding protein 1
基因别名: ARI; ARIH1; HUSSY-27; MOP6; UBCH7BP
Entrez Gene ID: (Human) 25820